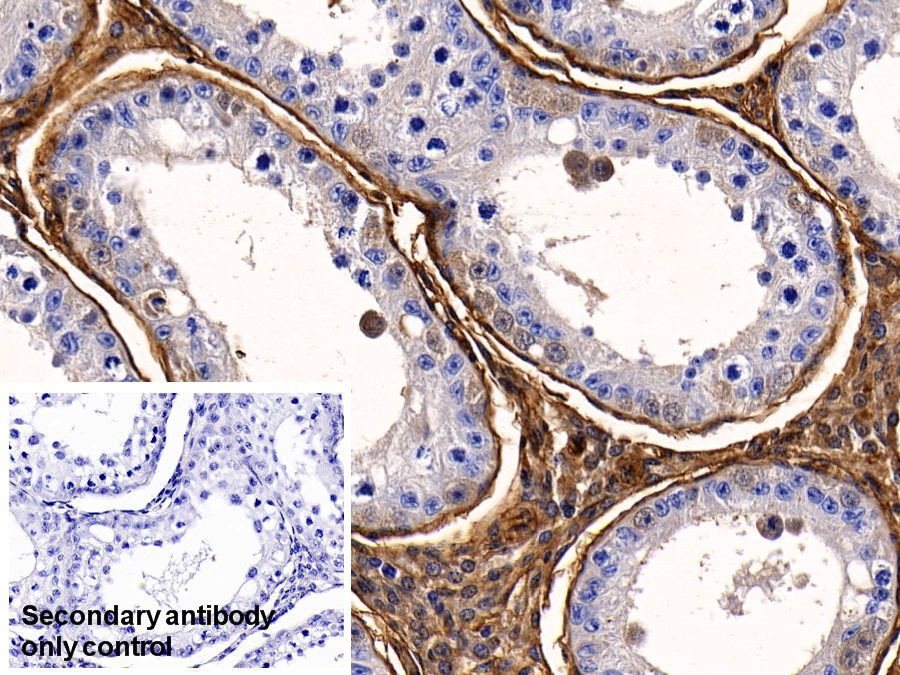

ELISA Kit for Insulin Like Growth Factor Binding Protein 4 (IGFBP4)


Product No.: CEA055Bo
Organism species: Bos taurus; Bovine (Cattle)

ELISA Kit for Interleukin 1 Alpha (IL1a)


Product No.: SEA071Bo
Organism species: Bos taurus; Bovine (Cattle)

ELISA Kit for Lectin Like Oxidized Low Density Lipoprotein Receptor 1 (LOX1)


Product No.: SEB859Bo
Organism species: Bos taurus; Bovine (Cattle)

Polyclonal Antibody to Factor Related Apoptosis (FAS)


Product No.: PAA030Bo01
Organism species: Bos taurus; Bovine (Cattle)
Polyclonal Antibody to Insulin Like Growth Factor Binding Protein 4 (IGFBP4)


Product No.: PAA055Bo01
Organism species: Bos taurus; Bovine (Cattle)

Polyclonal Antibody to Interleukin 1 Alpha (IL1a)


Product No.: PAA071Bo01
Organism species: Bos taurus; Bovine (Cattle)

Polyclonal Antibody to Cluster Of Differentiation 40 Ligand (CD40L)


Product No.: PAA119Bo01
Organism species: Bos taurus; Bovine (Cattle)
Polyclonal Antibody to Annexin V (ANXA5)


Product No.: PAA259Bo01
Organism species: Bos taurus; Bovine (Cattle)

Polyclonal Antibody to Lectin Like Oxidized Low Density Lipoprotein Receptor 1 (LOX1)


Product No.: PAB859Bo01
Organism species: Bos taurus; Bovine (Cattle)

Recombinant Factor Related Apoptosis (FAS)


Product No.: RPA030Bo01
Organism species: Bos taurus; Bovine (Cattle)
Recombinant Insulin Like Growth Factor Binding Protein 4 (IGFBP4)


Product No.: RPA055Bo01
Organism species: Bos taurus; Bovine (Cattle)

Recombinant Interleukin 1 Alpha (IL1a)


Product No.: RPA071Bo01
Organism species: Bos taurus; Bovine (Cattle)

Recombinant Cluster Of Differentiation 40 Ligand (CD40L)


Product No.: RPA119Bo01
Organism species: Bos taurus; Bovine (Cattle)


Recombinant Lectin Like Oxidized Low Density Lipoprotein Receptor 1 (LOX1)

